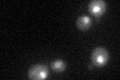
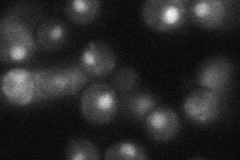
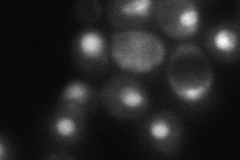
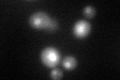
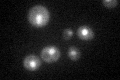

View description
Peptidylprolyl-cis/trans-isomerase (PPIase) specific for phosphorylated serine and threonine residues N-terminal to proline; regulates phosphorylation of the RNA polymerase II large subunit (Rpo21p) C-terminal domain
Localization:
Intensity:
Fold change:
Significance:
-
C’ GFP library in SD
nucleus46.56 -
N' NOP1pr-GFP in SD

nucleus211.624 -
N' TEF2pr-mCherry in SD

nucleus365.38 -
N' NATIVEpr-GFP in SD
nucleus31.5149 -
N' TEF2pr-VC and Cyto-VN in SD
nucleus61.6359 -
C’ GFP library in SD+DTT
nucleus48.961.05No -
C’ GFP library in SD+H2O2

nucleus46.50.99No -
C’ GFP library in Starvation Media
nucleus56.461.21No -
C’ GFP library on the background of Pup2-DaMP

nucleus -
C’ GFP library on the background of CCT mutant

nucleus43.05590.924525No
